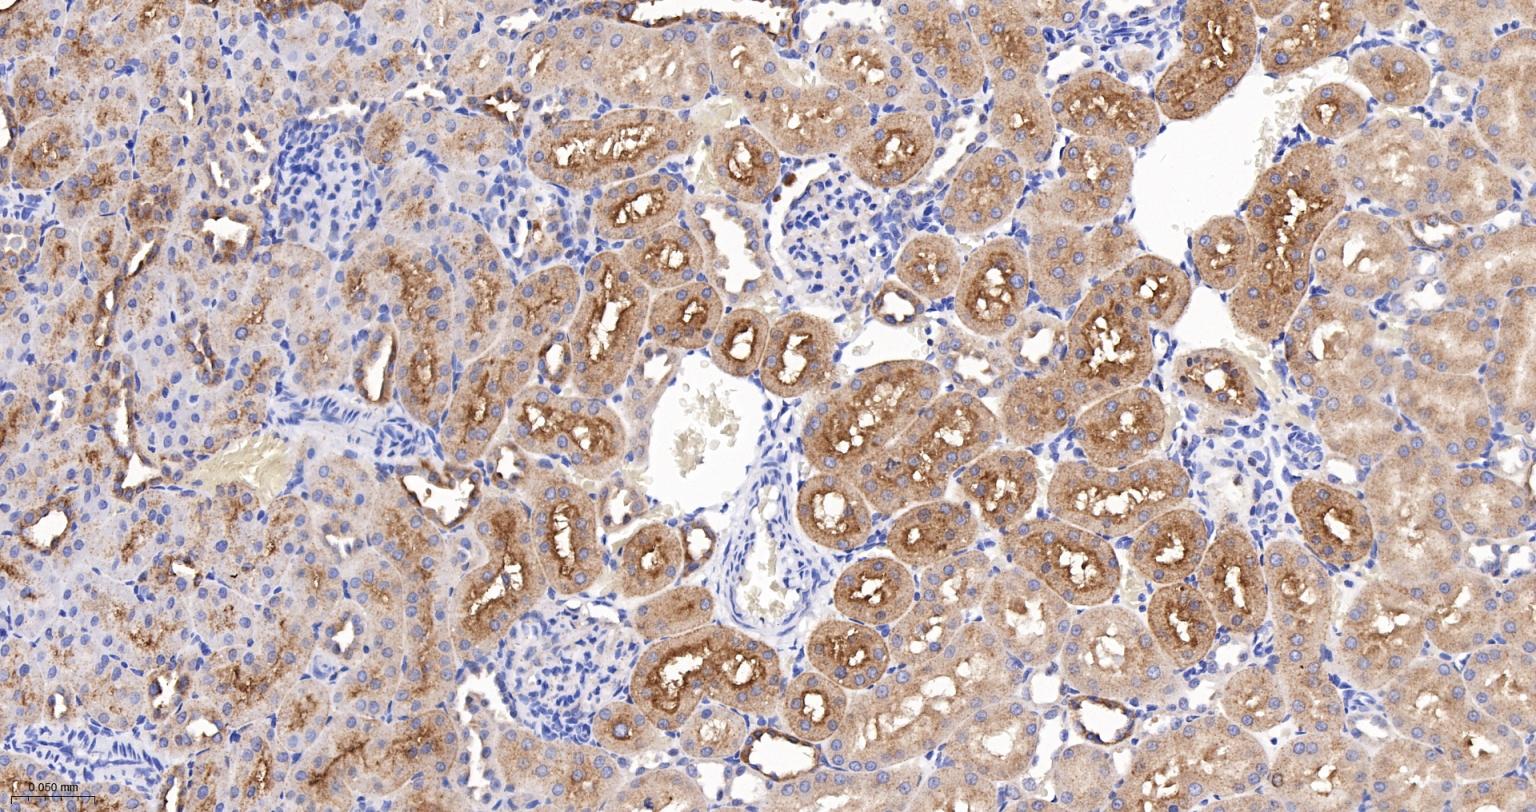
埃兹蛋白重组兔单抗-bsm-61424R

Ezrin Recombinant Rabbit mAb (一抗) - WB,IHC-P,IHC-F,IF | Bioss
Rrmab?兔单抗

货号:bsm-61424R
产品详情
相关标记
相关产品
相关文献
常见问题
概述
产品编号
bsm-61424R
产品类型
重组兔单抗
英文名称
Ezrin Recombinant Rabbit mAb
中文名称
埃兹蛋白重组兔单抗
英文别名
VIL2; CVIL; CVL; HEL-S-105; p81; EZRI_BOVIN; EZR; Cytovillin; Villin-2; EZRI_HUMAN; EZRI_MOUSE;
抗体来源
Rabbit
免疫原
A synthesized peptide derived from human Ezrin: 350-400/586
亚型
IgG
性状
Liquid
纯化方法
affinity purified by Protein A
克隆类型
Recombinant
克隆号
3A2
理论分子量
69 kDa
检测分子量
80 kDa
储存液
10mM phosphate buffered saline(pH 7.4) with 150mM sodium chloride, 0.05% BSA, 0.02% Proclin300 and 50% glycerol.
研究领域
SWISS
Gene ID
保存条件
Store at 4℃ for short term. Store at -20℃ for long term. Avoid repeated freeze/thaw cycles.
注意事项
This product as supplied is intended for research use only, not for use in human, therapeutic or diagnostic applications.
数据库链接
产品介绍
信号传导(Signaling Intermediates)
目前研究发现Ezrin蛋白与维持细胞的形状、极性、生长运动以及信号转导方面发挥重要作用,该蛋白与肿瘤的侵袭、转移有关。Erzin是埃兹蛋白(Ezrin)、根蛋白(Radxin)、膜突蛋白(Moesin)(ERM)家族成员,是一种位于细胞表面受体,黏附分子和肌动蛋白细胞骨架间的连接蛋白。Ezrin活性由N端和C端ERM缔合结构域间的分子内相互作用所调节。ERM家族在上皮细胞瘤中表达,它们可能在癌变过程中扮演重要角色。
目前研究发现Ezrin蛋白与维持细胞的形状、极性、生长运动以及信号转导方面发挥重要作用,该蛋白与肿瘤的侵袭、转移有关。Erzin是埃兹蛋白(Ezrin)、根蛋白(Radxin)、膜突蛋白(Moesin)(ERM)家族成员,是一种位于细胞表面受体,黏附分子和肌动蛋白细胞骨架间的连接蛋白。Ezrin活性由N端和C端ERM缔合结构域间的分子内相互作用所调节。ERM家族在上皮细胞瘤中表达,它们可能在癌变过程中扮演重要角色。
背景资料
Probably involved in connections of major cytoskeletal structures to the plasma membrane. In epithelial cells, required for the formation of microvilli and membrane ruffles on the apical pole. Along with PLEKHG6, required for normal macropinocytosis.

产品应用
| 应用 | 已检合格种属 | 预测种属 | 推荐稀释比例 |
|---|---|---|---|
| WB | Human | Mouse, Rat | 1:500-2000 |
| IHC-P | Human, Mouse, Rat | 1:100-500 | |
| IHC-F | Human, Mouse, Rat | 1:100-500 | |
| IF | Human, Mouse, Rat | 1:100-500 |
交叉反应
交叉反应: Human, Mouse, Rat
相关产品
暂无相关产品
靶标
基因名
EZR
蛋白名
Ezrin
亚基
Interacts with MPP5 and SLC9A3R2. Found in a complex with EZR, PODXL and SLC9A3R2 (By similarity). Interacts with MCC, PLEKHG6, PODXL, SCYL3/PACE1, SLC9A3R1 and TMEM8B. Interacts (when phosphorylated) with FES/FPS.
亚细胞定位
Apical cell membrane; Peripheral membrane protein; Cytoplasmic side. Cell projection. Cell projection, microvillus membrane; Peripheral membrane protein; Cytoplasmic side. Cell projection, ruffle membrane; Peripheral membrane protein; Cytoplasmic side. Cytoplasm, cell cortex. Cytoplasm, cytoskeleton. Note=Localization to the apical membrane of parietal cells depends on the interaction with MPP5. Localizes to cell extensions and peripheral processes of astrocytes. Microvillar peripheral membrane protein (cytoplasmic side).
组织特异性
Expressed in cerebral cortex, basal ganglia, hippocampus, hypophysis, and optic nerve. Weakly expressed in brain stem and diencephalon. Stronger expression was detected in gray matter of frontal lobe compared to white matter (at protein level). Component of the microvilli of intestinal epithelial cells. Preferentially expressed in astrocytes of hippocampus, frontal cortex, thalamus, parahippocampal cortex, amygdala, insula, and corpus callosum. Not detected in neurons in most tissues studied.
翻译后修饰
Phosphorylated by tyrosine-protein kinases. Phosphorylation by ROCK2 suppresses the head-to-tail association of the N-terminal and C-terminal halves resulting in an opened conformation which is capable of actin and membrane-bindin.
相似性
Contains 1 FERM domain.
功能
Probably involved in connections of major cytoskeletal structures to the plasma membrane. In epithelial cells, required for the formation of microvilli and membrane ruffles on the apical pole. Along with PLEKHG6, required for normal macropinocytosis.
同靶标产品
相关文献
提示: 发表研究结果有使用 bsm-61424R 时请让我们知道,以便我们可以引用参考文章。作为回馈,资料提供者将获得我们送上的小礼品。